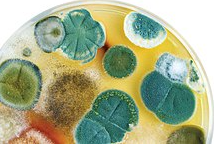

(a) 哪些垃圾不会被红蚯蚓转化为堆肥?
(b) 你在你的堆肥坑里看到过除了红蚯蚓以外的其他生物吗?如果是的,尝试找出它们的名称。画出它们的图片。
(a) 像碎玻璃、铝箔包装、塑料制品、塑料袋等不可降解的垃圾无法被红蚯蚓转化为堆肥。
(b) 是的,腐生生物如霉菌(白色、黑色或灰色的棉絮状斑块)和细菌(可以在显微镜下观察到),它们有助于分解生物可降解物质。
额外信息:含有植物和动物废弃物、食物残渣的垃圾,如果在坑或堆中放置不处理,会受到细菌、真菌等生物的作用而腐烂。
腐烂会导致肥料的形成。它是复杂分子转化为简单分子的过程,植物可以利用这些简单分子进行生长和发育。因此,一些有机物质的腐烂和转化为肥料称为堆肥。
蚯蚓堆肥是利用红蚯蚓或蚯蚓制作堆肥的方法。
以下是堆肥的步骤:
步骤 1 – 在花园的合适位置挖一个坑。
步骤 2 – 在坑底铺一层沙子。
步骤 3 – 将蔬菜皮和水果垃圾添加到坑中。
步骤 4 – 洒水保持湿润
步骤 5 – 将红蚯蚓放入坑中
步骤 6 – 用麻袋或草覆盖]

广告

 数据结构
数据结构 网络
网络 关系型数据库管理系统
关系型数据库管理系统 操作系统
操作系统 Java
Java iOS
iOS HTML
HTML CSS
CSS Android
Android Python
Python C 语言编程
C 语言编程 C++
C++ C#
C# MongoDB
MongoDB MySQL
MySQL Javascript
Javascript PHP
PHP